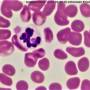
zytologie_-_anaplasmose_johannes_kriechbaumer_2018_.jpg

start
Medien-Manager
Dateiauswahl
Dateien in [Wurzel]
Thumbs.db is not a valid file name for DokuWiki - skipped

- 56aa8f5dbd921f71e69fd6ff73316397.png
- 1655×984
- 2023/09/03 12:32
- 1.4 MB

- 119804_diendorferstefanie_melon_20100101_0.jpg
- 2202×1506
- 2020/12/17 21:44
- 559.8 KB

- a78948048a1db2a33d47f76560836d1f.png
- 440×192
- 2021/03/17 15:23
- 250.1 KB

- achillessehnenruptur_schema.jpg
- 991×571
- 2020/10/29 14:55
- 90 KB
- amboss-systematik-der-bakterien.pdf
- 2020/10/29 14:54
- 119.5 KB

- anaesthesie_-_interkostalblock_quelle_unbekannt_.jpg
- 484×459
- 2020/10/29 14:55
- 64.8 KB

- anaesthesie-lokalanaesthesieepiduralmedikamente.png
- 2462×1935
- 2020/11/29 19:37
- 532.4 KB
- analbeutelresektion-macphail2008.pdf
- 2021/06/01 09:22
- 365.5 KB

- anatomie_-_ellbogengelenk_tobias_johnston_2012_.jpg
- 1292×674
- 2020/10/29 14:54
- 194.8 KB

- anatomie_-_karpalgelenk_zehen_tobias_johnston_2012_.jpg
- 1056×1842
- 2020/10/29 14:55
- 337.8 KB

- anatomie_-_leber_salomon_2008_.jpg
- 1451×732
- 2020/10/29 14:54
- 267.6 KB

- anatomie_-_lunge_fossum_2013_tobias_johnston_2012_.jpg
- 2039×900
- 2020/10/29 14:54
- 420.8 KB

- anatomie_-_milz_gefaessversorgung_fossum_2013_.jpg
- 614×858
- 2020/10/29 14:55
- 252.8 KB

- anatomie_-_nebennieren_blutgefaessversorgung_tobias_johnston_2012_.jpg
- 991×567
- 2020/10/29 14:55
- 102.5 KB

- anatomie_-_schilddruese_ultraschall_matoon_2015_.jpg
- 710×365
- 2020/10/29 14:54
- 61.5 KB

- anatomie_-_schultergelenk_tobias_johnston_2012_.jpg
- 947×685
- 2020/10/29 14:55
- 216.3 KB

- anatomie_-_tarsalgelenk_tobias_johnston_2012_.jpg
- 1109×1581
- 2020/10/29 14:54
- 257.2 KB

- anatomie_-_thorax_tobias_johnston_2012_.jpg
- 1698×752
- 2020/10/29 14:54
- 479.7 KB

- anatomie-kran.kreuzband.jpg
- 1771×3087
- 2022/08/12 08:20
- 1.6 MB

- anisokorie_1.png
- 1366×768
- 2020/11/06 22:35
- 191.3 KB

- anisokorie.png
- 1366×768
- 2020/11/06 22:33
- 191.3 KB

- anteile_achillessehne.jpg
- 1071×509
- 2020/10/29 14:54
- 90.8 KB

- antibiotikagruppen_bm_fuer_gesundheit_2013_.png
- 1240×5938
- 2020/10/29 14:55
- 573.7 KB

- antibiotikakombinationen_loescher_et_al._2003_.jpg
- 1108×789
- 2020/10/29 14:55
- 217 KB

- auge-entropiumkatzepauli2018.jpg
- 2449×2101
- 2020/11/02 18:59
- 1 MB

- blut_-_anaemie.png
- 1156×731
- 2020/10/29 14:54
- 30.6 KB

- blut_-_angeborene_koagulopathien_idexx_2008_.jpg
- 750×709
- 2020/10/29 14:55
- 174.9 KB

- blut_-_gerinnung_intrinisch_und_extrinsisch_idexx_2008_.jpg
- 1323×763
- 2020/10/29 14:54
- 155.3 KB

- blut_-_interpretation_gerinnungstests_idexx_2008_.jpg
- 2160×1107
- 2020/10/29 14:54
- 331.7 KB

- blutkreislauf_-_pss_fossum_2013_.jpg
- 1259×377
- 2020/10/29 14:54
- 97.3 KB
- bullaosteotomie_katze.pdf
- 2020/10/29 14:55
- 220.9 KB

- cblo_raske_et_al._2013_.jpg
- 505×790
- 2020/10/29 14:55
- 121.1 KB

- cpr.jpg
- 636×768
- 2021/06/26 19:34
- 93.8 KB

- cpr1algorithm.jpg
- 1000×1533
- 2021/06/26 19:39
- 289.4 KB

- cpr2rosc.jpg
- 1000×1503
- 2021/06/26 19:39
- 305.6 KB

- cprcompressioncat.jpg
- 533×1166
- 2021/06/26 19:39
- 90.9 KB

- cprcompressiondog.jpg
- 533×1441
- 2021/06/26 19:40
- 111.6 KB

- cprdrugs.png
- 1405×939
- 2021/06/26 19:39
- 1.1 MB

- ct_-_fensterung_schad_2015_.jpg
- 1216×697
- 2020/10/29 14:55
- 73 KB

- ct_-_pss-suche_m2_2019_.jpg
- 495×207
- 2020/10/29 14:54
- 10.7 KB

- dermatologie_-_juckreizschwelle_m2_2018_.jpg
- 1171×737
- 2020/10/29 14:55
- 172.2 KB

- ductus_thoracicus_anatomie_1_tobias_johnston_2012_.jpg
- 1290×1176
- 2020/10/29 14:55
- 379.2 KB

- ductus_thoracicus_op_1_orton_1995_.jpg
- 1189×701
- 2020/10/29 14:54
- 439.3 KB

- ekg_-_hyperkaliaemie_battaglia_2016_.jpg
- 815×913
- 2020/10/29 14:54
- 695 KB

- endokrinologie_-_nebennierentumore_und_symptome_tobias_johnston_2012_.jpg
- 1055×444
- 2020/10/29 14:54
- 88.7 KB

- episioplastik.jpg
- 973×318
- 2021/03/01 18:46
- 72.4 KB

- ernaehrungbeianorexie.jpg
- 1052×1446
- 2020/10/29 14:54
- 344.8 KB

- femurkopfresektion_schnittfuehrung_tobias_2012_.jpg
- 848×898
- 2020/10/29 14:55
- 293.7 KB
- fic_merkblatt.pdf
- 2021/03/15 14:39
- 115.1 KB
- fipheilbarpedersenm2019.pdf
- 2020/10/29 14:54
- 451 KB

- git_-_ple.jpg
- 1174×489
- 2020/10/29 14:54
- 85 KB

- git_-_therapieschema_helicobacter_pylori_2018_.jpg
- 936×639
- 2020/10/29 14:54
- 150.2 KB
- glasgow_coma_scale.pdf
- 2020/10/29 14:55
- 243.7 KB

- grading_brachycephalensyndrom_poncet_et_al._2005_.jpg
- 1071×350
- 2020/10/29 14:54
- 140.4 KB

- gynaekologie_-_zyklus_huendin_hormonbestimmung_laboklin_2018_.jpg
- 1255×862
- 2020/10/29 14:55
- 112.6 KB

- hd-grade.jpg
- 900×537
- 2020/10/29 14:54
- 118.1 KB

- horner1.png
- 1108×831
- 2020/11/06 22:11
- 1.1 MB

- hypertrophe_osteopathie_verursacht_durch_ein_prostatakarzinom_m1_2018_.jpg
- 1976×1482
- 2020/10/29 14:54
- 1.3 MB
- impfleitlinien_fuer_kleintiere_oetk_2017_.pdf
- 2020/10/29 14:55
- 1.3 MB

- impfschemata_hund_katze.png
- 1888×1637
- 2020/10/29 14:55
- 700.1 KB
- info_monitoring_vit_k_therapie_bei_gerinnungsstoerungen.pdf
- 2020/10/29 14:55
- 148.8 KB

- innere_-_blutgruppen_katze.jpg
- 960×720
- 2020/10/29 14:54
- 90.5 KB

- innere_sirs_sepsis.jpg
- 1080×743
- 2020/10/29 14:55
- 112.7 KB

- koenig_liebich2001.jpg
- 1970/01/01 01:00
- 0 B

- kniegelenksanatomie_-_meniscus_und_baender_tobias_johnston_2012_.jpg
- 629×862
- 2020/10/29 14:54
- 218.2 KB

- kniegelenksanatomie_salomon_2008_.jpg
- 465×892
- 2020/10/29 14:54
- 151.8 KB

- kniegelenksanatomie_singh_saunders_veterinary_anatomy_flash_cards_2nd_ed_2015_.jpg
- 534×1053
- 2020/10/29 14:54
- 89.5 KB
- kniegelenksluxationperry2014.pdf
- 2021/10/06 16:36
- 540.5 KB

- labor_-_calziumhaushalt.png
- 1360×1163
- 2020/10/29 14:55
- 212.9 KB

- labor_-_nt-probnp-test_cardiac_education_group_2014_.jpg
- 1653×440
- 2020/10/29 14:54
- 334.9 KB

- labor_acth-stimulationstest_interpretation_riegler_m_2018_.jpg
- 1172×324
- 2020/10/29 14:54
- 125.4 KB

- labor_calziumhaushalt.jpg
- 610×450
- 2020/10/29 14:55
- 39.3 KB

- labor_low-dose-dexmethason-suppressionstest_interpretation_riegler_m_2018_.jpg
- 1059×482
- 2020/10/29 14:54
- 170.8 KB

- lateraler_zugang_zum_hueftgelenk_decamp_et_al._2016_.jpg
- 985×1567
- 2020/10/29 14:54
- 590.4 KB

- laterales_halteband_schema_fossum_2013_.jpg
- 773×836
- 2020/10/29 14:54
- 141.6 KB

- mandibulektomie_-_kessler_.jpg
- 1762×574
- 2020/10/29 14:54
- 183.5 KB

- maxillektomie_-_kessler_.jpg
- 2363×1454
- 2020/10/29 14:55
- 551.9 KB

- meniscus_schaden_tobias_johnston_2012_.jpg
- 704×960
- 2020/10/29 14:54
- 80.2 KB

- meniscus_schaden_ursache_tobias_johnston_2012_.jpg
- 652×750
- 2020/10/29 14:54
- 176.2 KB

- meniscus-release_fossum_2013_.jpg
- 783×929
- 2020/10/29 14:54
- 202.2 KB

- meniscus-release_tobias_johnston_2012_.jpg
- 1263×886
- 2020/10/29 14:54
- 112.3 KB

- neurochirurgie_-_anatomie_lw_fossum_2013_.jpg
- 807×484
- 2020/10/29 14:54
- 140.7 KB

- neurochirurgie_-_blutversorgung_hws_tobias_2012_.jpg
- 1399×727
- 2020/10/29 14:54
- 327.9 KB

- neurochirurgie_-_ces_anatomie_fossum_2013_.jpg
- 1735×679
- 2020/10/29 14:55
- 189.8 KB

- neurochirurgie_-_ces_stabilisierung_2_early_et_al._2015_.jpg
- 931×641
- 2020/10/29 14:55
- 147.2 KB

- neurochirurgie_-_ces_stabilisierung_3_smolders_et_al._2010_.jpg
- 1018×571
- 2020/10/29 14:55
- 122.1 KB

- neurochirurgie_-_ces_stabilisierung_early_et_al._2015_.jpg
- 764×782
- 2020/10/29 14:54
- 140 KB

- neurochirurgie_-_dorsale_laminektomie_ces_1_meij_bergknut_2010_.jpg
- 663×498
- 2020/10/29 14:54
- 146.4 KB

- neurochirurgie_-_dorsale_laminektomie_ces_2_meij_bergknut_2010_.jpg
- 1604×315
- 2020/10/29 14:54
- 165.5 KB

- neurochirurgie_-_dorsale_laminektomie_ces_fossum_2013_.jpg
- 995×743
- 2020/10/29 14:54
- 137.4 KB

- neurochirurgie_-_dorsale_laminektomie_hws_fossum_2013_.jpg
- 1343×694
- 2020/10/29 14:54
- 197.3 KB

- neurochirurgie_-_fasettektomie_m2_2018_.jpg
- 702×411
- 2020/10/29 14:54
- 51.7 KB

- neurochirurgie_-_foraminotomie_goedde_steffen_2007_.jpg
- 552×660
- 2020/10/29 14:54
- 124.9 KB

- neurochirurgie_-_foraminotomie_post-op_1_m2_2018_.jpg
- 1283×961
- 2020/10/29 14:55
- 320.5 KB

- neurochirurgie_-_hemilaminektomie_fossum_2013_.jpg
- 597×448
- 2020/10/29 14:55
- 111.7 KB

- neurochirurgie_-_hemilaminektomie_vs._minihemilaminektomie.jpg
- 1762×302
- 2020/10/29 14:54
- 62.2 KB

- neurochirurgie_-_korpektomie_1_fossum_2013_.jpg
- 650×383
- 2020/10/29 14:54
- 77.3 KB

- neurochirurgie_-_korpektomie_2.jpg
- 1435×784
- 2020/10/29 14:55
- 225.8 KB

- neurochirurgie_-_korpektomie_3_forterre_2017_.jpg
- 704×704
- 2020/10/29 14:55
- 102.6 KB

- neurochirurgie_-_lagerung_ces-operationen_fossum_2013_.jpg
- 465×293
- 2020/10/29 14:54
- 59.7 KB

- neurochirurgie_-_lagerung_dorsale_laminektomie_hws_fossum_2013_.jpg
- 655×471
- 2020/10/29 14:55
- 57.3 KB

- neurochirurgie_-_lagerung_hemilaminektomie_tobias_2012_.jpg
- 641×626
- 2020/10/29 14:54
- 237.8 KB

- neurochirurgie_-_minihemilaminektomie_fossum_2013_.jpg
- 567×425
- 2020/10/29 14:54
- 59.8 KB

- neurochirurgie_-_nerven_cauda-equina_sharp_wheeler_2005_.jpg
- 902×652
- 2020/10/29 14:54
- 448.9 KB

- neurochirurgie_-_nervenhaken_und_proben_tobias_2012_.jpg
- 601×418
- 2020/10/29 14:54
- 212.6 KB

- neurochirurgie_-_prognose_dorsale_laminektomie_ces_meij_bergknut_2010_.jpg
- 1169×861
- 2020/10/29 14:55
- 209.6 KB

- neurochirurgie_-_ursachen_cauda-equina_1_sharp_wheeler_2005_.jpg
- 1157×822
- 2020/10/29 14:54
- 234.1 KB

- neurochirurgie_-_zugang_fasettektomie_hws_tobias_2012_.jpg
- 819×973
- 2020/10/29 14:54
- 336.7 KB

- neurochirurgie_-_zugang_hemilaminektomie_korpektomie_fossum_2013_.jpg
- 1462×1404
- 2020/10/29 14:54
- 376.2 KB

- neurochirurgie_-d_orsale_laminektomie_hws_tobias_2012_.jpg
- 638×509
- 2020/10/29 14:54
- 97.7 KB

- neurologie_-_blaseninnervation_tobias_2012_.jpg
- 1486×1333
- 2020/10/29 14:54
- 229.6 KB

- neurologie_-_gehirn_symptome_und_differentialdiagnosen_esavs_2018_.jpg
- 1855×2186
- 2020/10/29 14:55
- 843.3 KB

- neurologie_-_gehirnnerven.png
- 2250×1350
- 2020/10/29 14:55
- 1.7 MB

- neurologie_-_haltungs-_und_stellreaktionen_esavs_2018_.jpg
- 1264×550
- 2020/10/29 14:54
- 107.5 KB

- neurologie_-_hydrocephalus_internus_m2_2018_.jpg
- 2476×1561
- 2020/10/29 14:55
- 374.5 KB

- neurologie_-_innervation_extremitaeten.jpg
- 1713×749
- 2020/10/29 14:54
- 247 KB

- neurologie_-_kopfnervenfunktion_esavs_2018_.jpg
- 1110×664
- 2020/10/29 14:55
- 289.7 KB

- neurologie_-_kopfnervenfunktion_tests_esavs_2018_.jpg
- 1105×679
- 2020/10/29 14:55
- 197.9 KB

- neurologie_-_liquoranalyse_1_lorenz_coates_kent_2011_.jpg
- 1477×1133
- 2020/10/29 14:55
- 393.9 KB

- neurologie_-_liquorpunktion_cisternal_fossum_2013_.jpg
- 2128×727
- 2020/10/29 14:54
- 233.8 KB

- neurologie_-_liquorpunktion_lumbal_morgan_2008_fossum_2013_.jpg
- 1687×529
- 2020/10/29 14:54
- 124.7 KB

- neurologie_-_myelographie_bei_raumforderung_1_sharp_wheeler_2005_.jpg
- 1486×732
- 2020/10/29 14:55
- 190.7 KB

- neurologie_-_myelographie_bei_raumforderung.jpg
- 1352×946
- 2020/10/29 14:55
- 220.2 KB

- neurologie_-_nerven_cauda_equina_meij_bergknut_2010_.jpg
- 585×1081
- 2020/10/29 14:55
- 312.2 KB

- neurologie_-_neurolikalisation_rueckenmark.jpg
- 649×355
- 2020/10/29 14:54
- 51.3 KB

- neurologie_-_neurologischer_untersuchungsgang_esavs_esavs_2018_.jpg
- 1481×881
- 2020/10/29 14:54
- 255 KB

- neurologie_-_neurolokalisation_schema_esavs_2018_.jpg
- 1123×796
- 2020/10/29 14:54
- 204.3 KB

- neurologie_-_panniculusreflex_lorenz_2011_.jpg
- 728×546
- 2020/10/29 14:55
- 61.6 KB

- neurologie_-_pupillarreflex_yaw_tsai_touro_university_.png
- 805×1049
- 2020/10/29 14:54
- 103 KB

- neurologie_-_pupillen_m2_2018_.jpg
- 971×878
- 2020/10/29 14:54
- 226.7 KB

- neurologie_-_quadrigmenale_subarachnoidale_zyste_dewey_2008_m2_2018_.jpg
- 1692×615
- 2020/10/29 14:54
- 159.6 KB

- neurologie_-_reflexbogen_sharp_wheeler_2005_.jpg
- 695×509
- 2020/10/29 14:54
- 118.2 KB

- neurologie_-_rueckenmark_propriozeption_www.promotionphotos.info_2018_.jpg
- 2293×1542
- 2020/10/29 14:54
- 400.8 KB

- neurologie_-_sensible_invervation_extremitaeten_dewey_costa_2016_.jpg
- 1413×1838
- 2020/10/29 14:54
- 700.9 KB

- neurologie_-_spinale_reflexe_extremitaeten_esavs_2018_.jpg
- 2111×649
- 2020/10/29 14:54
- 248.9 KB

- neurologie_-_syringomyelie_mr_schmidt_2013_.jpg
- 1577×1234
- 2020/10/29 14:54
- 781.9 KB

- neurologie_-_unteres_und_oberes_motoneuron_sharp_wheeler_2005_.jpg
- 691×396
- 2020/10/29 14:54
- 56.4 KB

- neurologie_-_ventrikelsystem_quizlet.com_2018_.jpg
- 1024×416
- 2020/10/29 14:54
- 115.4 KB

- neurologie_-_vestibularsyndrom_zentral_peripher_paradox_esavs_2018_.jpg
- 926×778
- 2020/10/29 14:54
- 224.3 KB

- neurologie-bandscheibenvorfallchirurgievs.konservativforterre2021.jpg
- 2956×1093
- 2021/03/10 10:47
- 278.8 KB

- neurologie-iatrogenenervenschaedenforterre2021.jpg
- 2554×1753
- 2021/02/27 16:20
- 451.7 KB

- neurologie-plexusabrissshemaforterre2021.jpg
- 2350×970
- 2021/02/27 16:03
- 320.6 KB

- neurologie-ursachemonopareseforterre2021.jpg
- 1395×1045
- 2021/02/27 16:24
- 112.3 KB

- notfallmedizin_-_zvk_taylor_2016_.jpg
- 1776×1355
- 2020/10/29 14:55
- 560.8 KB

- onkologie_-_paraneoplastische_syndrome_28quelle_unbekannt_29_1.jpg
- 617×906
- 2020/10/29 14:54
- 167.8 KB

- onkologie_-_tumorstaging_1_dobson_lascelles_2010_.jpg
- 760×760
- 2020/10/29 14:54
- 61.4 KB

- op_-_acetabulumfraktur_mit_knochenzement_piermattei_2017_.jpg
- 2075×501
- 2020/10/29 14:54
- 158.9 KB

- op_-_acetabulumfraktur_pins_zugschrauben_piermattei_2017_.jpg
- 2309×360
- 2020/10/29 14:54
- 125.7 KB

- op_-_acetabulumfraktur_reposition_piermattei_2017_.jpg
- 1615×508
- 2020/10/29 14:55
- 112.4 KB

- op_-_acetabulumfraktur_verplattung_piermattei_2017_.jpg
- 2597×613
- 2020/10/29 14:54
- 206.8 KB

- op_-_achillessehnenruptur_mit_tendon-plating_zellner_et_al._2017_.jpg
- 1230×495
- 2020/10/29 14:54
- 152.4 KB

- op_-_amputation_hinterextremitaet_im_femur_fossum_2013_.jpg
- 915×976
- 2020/10/29 14:55
- 226.5 KB

- op_-_amputation_hinterextremitaet_im_hueftgelenk_fossum_2013_.jpg
- 876×1241
- 2020/10/29 14:54
- 292.9 KB

- op_-_amputation_vorderextremitaet_fossum_2013_.jpg
- 869×1223
- 2020/10/29 14:55
- 302.4 KB

- op_-_analbeutelresektion_fossum_2013_.jpg
- 1575×818
- 2020/10/29 14:54
- 216.2 KB

- op_-_arthrodese_karpalgelenk.jpg
- 515×555
- 2020/10/29 14:54
- 44.4 KB

- op_-_atlantoaxiale_subluxation_-_anatomie_tobias_2012_fossum_2013_.jpg
- 1528×332
- 2020/10/29 14:54
- 114.9 KB

- op_-_atlantoaxiale_subluxation_-_dorsale_zuggurtung_tobias_2012_.jpg
- 1215×305
- 2020/10/29 14:54
- 69.6 KB

- op_-_atlantoaxiale_subluxation_-_transartikulaere_implantatsetzung_leblond_2017_.jpg
- 1743×454
- 2020/10/29 14:54
- 200.5 KB

- op_-_atlantoaxiale_subluxation_-_transartikulaere_verschraubung_tobias_2012_fossum_2013_.jpg
- 1664×662
- 2020/10/29 14:54
- 156.3 KB

- op_-_atlantoaxiale_subluxation_-_ventrale_versteifung_mit_schrauben_und_pmma_tobias_2012_.jpg
- 2008×522
- 2020/10/29 14:54
- 197.4 KB

- op_-_billroth_i_ii_fossum_2013_.jpg
- 1636×850
- 2020/10/29 14:54
- 223.6 KB

- op_-_caud._kreuzbandriss_-_extrakapsulaeres_halteband_fossum_2013_.jpg
- 581×584
- 2020/10/29 14:54
- 32.4 KB

- op_-_cerclagen_grundlagen_decamp_2016_.jpg
- 1649×535
- 2020/10/29 14:55
- 210.1 KB

- op_-_cerclagen_interfragmentaer_decamp_2016_.jpg
- 845×730
- 2020/10/29 14:54
- 125.7 KB

- op_-_cran._kreuzbandriss_-_laterales_halteband_fossum_2013_.jpg
- 1789×610
- 2020/10/29 14:54
- 135.3 KB

- op_-_darmnaht_fossum_2013_.jpg
- 1829×793
- 2020/10/29 14:54
- 245 KB

- op_-_darmresektion_1_fossum_2013_.jpg
- 2209×1179
- 2020/10/29 14:55
- 462.7 KB

- op_-_darmresektion_stapler_fossum_2013_.jpg
- 780×792
- 2020/10/29 14:54
- 130.7 KB

- op_-_ektopische_ureteren_formen_fossum_2013_.jpg
- 1376×504
- 2020/10/29 14:55
- 122.2 KB

- op_-_femurfraktur_-_avulsion_trochanter_mayor_piermattei_2017_.jpg
- 1403×548
- 2020/10/29 14:54
- 115.5 KB

- op_-_femurfraktur_-_diaphysenfraktur_-_kompressions-_neutralisations-_ueberbrueckungsplatte_fossum_2013_.jpg
- 569×786
- 2020/10/29 14:54
- 90 KB

- op_-_femurfraktur_-_distale_epiphysiolyse_femur_piermattei_2017_.jpg
- 1845×636
- 2020/10/29 14:55
- 195.1 KB

- op_-_femurfraktur_-_distale_femurfraktur_klassifizierung_tobias_2012_.jpg
- 1570×643
- 2020/10/29 14:54
- 169.6 KB

- op_-_femurfraktur_-_femurhalsfraktur_mit_zugschraube_und_pins_tobias_2012_piermattei_2017_fossum_2013_.jpg
- 2153×841
- 2020/10/29 14:55
- 186.1 KB

- op_-_femurfraktur_-_komplexe_proximale_femurfraktur_piermattei_2017_.jpg
- 680×370
- 2020/10/29 14:54
- 59.6 KB

- op_-_femurfraktur_-_proximale_femurfraktur_blutversorgung_tobias_2012_.jpg
- 1677×845
- 2020/10/29 14:54
- 201.3 KB

- op_-_femurfraktur_-_proximale_femurfraktur_klassifizierung_tobias_2012_.jpg
- 1496×426
- 2020/10/29 14:54
- 115.9 KB

- op_-_femurfraktur_-_proximale_femurkopffrakturen_piermattei_2017_.jpg
- 2977×985
- 2020/10/29 14:54
- 452.9 KB

- op_-_fersenkappenluxation_martin_riegler_2018_.jpg
- 1734×591
- 2020/10/29 14:54
- 231.3 KB

- op_-_fraesen_und_raeumen_ventral-slot_fossum_2013_.jpg
- 1616×666
- 2020/10/29 14:54
- 236.1 KB

- op_-_gastropexie_fossum_2013_.jpg
- 1048×1051
- 2020/10/29 14:54
- 339.5 KB

- op_-_gastrotomie-sonde_tobias_2012_.jpg
- 1559×752
- 2020/10/29 14:55
- 620.1 KB

- op_-_gaumenspalte_oronasale_fistel_fossum_2013_.jpg
- 1004×3281
- 2020/10/29 14:54
- 705.7 KB

- op_-_humerus_-_diaphysenfraktur_fossum_2013_permattei_2017_.jpg
- 3015×860
- 2020/10/29 14:55
- 335.1 KB

- op_-_humerus_-_distale_humerusfraktur_kondylusfraktur_tobias_2012_.jpg
- 2815×590
- 2020/10/29 14:54
- 160.3 KB

- op_-_humerus_-_distaler_zugang_permattei_2017_.jpg
- 1456×771
- 2020/10/29 14:54
- 187.8 KB

- op_-_humerus_-_kondylusfraktur_zugschraubenplatzierung_tobias_2012_permattei_2017_.jpg
- 1714×779
- 2020/10/29 14:55
- 177.5 KB

- op_-_humerus_-_lateraler_zugang_fossum_2013_permattei_2017_.jpg
- 2365×896
- 2020/10/29 14:54
- 394 KB

- op_-_humerus_-_medialer_zugang_fossum_2013_permattei_2017_.jpg
- 1670×640
- 2020/10/29 14:55
- 208.6 KB

- op_-_humerus_-_zugang_fuer_platten_permattei_2017_.jpg
- 1091×659
- 2020/10/29 14:54
- 135.5 KB

- op_-_humerus_proximale_frakturen_tobias_2012_permattei_2017_.jpg
- 2869×1230
- 2020/10/29 14:54
- 244.9 KB

- op_-_iliosakralluxation_bilateral_m2_.jpg
- 1942×716
- 2020/10/29 14:54
- 246.2 KB

- op_-_iliosakralluxation_minimalinvasiv_m2_.jpg
- 3516×836
- 2020/10/29 14:55
- 406.5 KB

- op_-_iliosakralluxation_minimalinvasiv_martin_riegler_2018_.jpg
- 3516×836
- 2020/10/29 14:54
- 406.5 KB

- op_-_iliosakralluxation_minimalinvasiv_pelvic_pinning_m2_.jpg
- 1494×491
- 2020/10/29 14:54
- 107.2 KB

- op_-_ilizarov-fixateur_decamp_2016_.jpg
- 389×686
- 2020/10/29 14:54
- 123.6 KB

- op_-_inguinarle_hernie_fossum_2013_.jpg
- 1659×1163
- 2020/10/29 14:55
- 411.2 KB

- op_-_interdental_wiring_0_holmstrom_2007_.jpg
- 2747×763
- 2020/10/29 14:54
- 280.7 KB

- op_-_interdental_wiring_1_holmstrom_2007_.jpg
- 2161×545
- 2020/10/29 14:55
- 150.5 KB

- op_-_interdental_wiring_2_holmstrom_2007_.jpg
- 2161×545
- 2020/10/29 14:54
- 170.8 KB

- op_-_interdental_wiring_3_holmstrom_2007_.jpg
- 2502×545
- 2020/10/29 14:54
- 184.6 KB

- op_-_invagination_fossum_2013_.jpg
- 760×651
- 2020/10/29 14:54
- 45.5 KB

- op_-_ipa_prognose_vezzoni_2016_.jpg
- 972×725
- 2020/10/29 14:54
- 85.1 KB

- op_-_ipa_zugschraube.jpg
- 1446×745
- 2020/10/29 14:54
- 94.8 KB

- op_-_kniegelenksluxation_-_temporaere_knieversteifung.jpg
- 210×318
- 2020/10/29 14:54
- 8 KB

- op_-_kolektomie_fossum_2013_.jpg
- 781×871
- 2020/10/29 14:54
- 97.1 KB

- op_-_kolopexie_fossum_2013_.jpg
- 533×810
- 2020/10/29 14:54
- 64.6 KB

- op_-_lagerung_ventral-slot_fossum_2013_.jpg
- 544×547
- 2020/10/29 14:54
- 45.7 KB

- op_-_laterale_thorakotomie_zugaenge_gomez_et_al._2013_.jpg
- 885×726
- 2020/10/29 14:54
- 64.2 KB

- op_-_leberresektion_fossum_2013_.jpg
- 1532×800
- 2020/10/29 14:55
- 236.7 KB

- op_-_lokalisation_ventral-slot_fossum_2013_.jpg
- 1687×631
- 2020/10/29 14:54
- 128 KB

- op_-_magendrehung_1_tobias_2012_.jpg
- 1083×430
- 2020/10/29 14:54
- 99.3 KB

- op_-_mastektomie_fossum_2013_.jpg
- 785×1136
- 2020/10/29 14:55
- 213.6 KB

- op_-_metakarpalfraktur_fitzpatrick_et_al._2010_.jpg
- 1640×513
- 2020/10/29 14:55
- 130.7 KB

- op_-_metakarpalfraktur_fossum_2013_.jpg
- 1445×507
- 2020/10/29 14:54
- 123.7 KB

- op_-_mukozele_-_resektion_glandula_mandibularis_fossum_2013_kaiser_2006_.jpg
- 2123×986
- 2020/10/29 14:55
- 353.6 KB

- op_-_mukozele_-_symptome_und_massnahmen_fossum_2013_tabelle_modifiziert_martin_riegler_2017_.jpg
- 2043×907
- 2020/10/29 14:54
- 285.9 KB

- op_-_mukozele_-_zytologie_tobias_johnston_2012_martin_riegler_2017_.jpg
- 1860×1156
- 2020/10/29 14:54
- 290.5 KB

- op_-_mukozele_anatomie_2_tobias_johnston_2012_fossum_2013_.jpg
- 1670×589
- 2020/10/29 14:54
- 153.7 KB

- op_-_mukozele_anatomie_tobias_johnston_2012_.jpg
- 2039×847
- 2020/10/29 14:55
- 372 KB

- op_-_mukozele_ranula_und_sublinguale_mukozele_tobias_johnston_2012_fossum_2013_.jpg
- 1543×494
- 2020/10/29 14:55
- 192.2 KB

- op_-_nasenschlund-sonde_fossum_2012_.jpg
- 956×1533
- 2020/10/29 14:54
- 526.9 KB

- op_-_nasenschlund-sonde_tobias_2013_.jpg
- 1525×1469
- 2020/10/29 14:54
- 596.9 KB

- op_-_nasenspiegelresektion.jpg
- 2129×619
- 2020/10/29 14:54
- 326.5 KB

- op_-_nebennierentumorresektion_mediane_laparotomie_tobias_johnston_2012_fossum_2013_.jpg
- 2140×778
- 2020/10/29 14:55
- 200.9 KB

- op_-_nebennierentumorresektion_mit_gefaessinvasion_tobias_johnston_2012_.jpg
- 959×526
- 2020/10/29 14:55
- 108.7 KB

- op_-_nebennierentumorresektion_paralumbar_laparotomie_tobias_johnston_2012_fossum_2013_.jpg
- 1529×640
- 2020/10/29 14:55
- 135.1 KB

- op_-_neoureterostomie_fossum_2013_.jpg
- 1344×502
- 2020/10/29 14:55
- 140.5 KB

- op_-_oesophagusnaht.jpg
- 692×296
- 2020/10/29 14:55
- 25.5 KB

- op_-_osteotomie_becken_fossum_2013_.jpg
- 1870×1128
- 2020/10/29 14:54
- 362.6 KB

- op_-_othaematom_drain_bei_kleinem_haematom_fossum_2013_.jpg
- 705×457
- 2020/10/29 14:54
- 63 KB

- op_-_othaematom_op_standard_fossum_2013_.jpg
- 839×552
- 2020/10/29 14:54
- 64.7 KB

- op_-_othaematom_puch-technik_smeak_dd_2006_.jpg
- 1676×559
- 2020/10/29 14:55
- 155.3 KB

- op_-_patellafraktur_tobias_johnston_2012_.jpg
- 1252×1867
- 2020/10/29 14:55
- 286.5 KB

- op_-_perinealhernie_fossum_2013_.jpg
- 1441×790
- 2020/10/29 14:55
- 307.6 KB

- op_-_praepubischer_katheter_meeson_corr_2011_.jpg
- 2379×3174
- 2020/10/29 14:55
- 823 KB

- op_-_praepupischer_katheter_fossum_2013_.jpg
- 1407×815
- 2020/10/29 14:54
- 207.6 KB

- op_-_proptosis_bulbi_fossum_2013_.jpg
- 759×638
- 2020/10/29 14:54
- 127.3 KB

- op_-_proximale_ulnafraktur_tobias_johnston_2012_.jpg
- 2856×1132
- 2020/10/29 14:54
- 435.7 KB

- op_-_radius-ulna-fraktur_fossum_2013_.jpg
- 3162×1175
- 2020/10/29 14:54
- 534.3 KB

- op_-_resektion_rektum_-_svenson_procedur.jpg
- 2985×436
- 2020/10/29 14:54
- 181.7 KB

- op_-_resektion_rektumtumor_fossum_2013_.jpg
- 2263×720
- 2020/10/29 14:54
- 204.3 KB

- op_-_ruptur_lig._retctum_patellae_tobias_johnston_2012_.jpg
- 653×876
- 2020/10/29 14:55
- 89.4 KB

- op_-_rush-pinning_decamp_et_al._2016_.jpg
- 1550×987
- 2020/10/29 14:54
- 270.2 KB

- op_-_schauben_und_bohrer_synthes_2018_.jpg
- 1699×2176
- 2020/10/29 14:54
- 561.1 KB

- op_-_schulterarthrodese_decamp_et_al._2016_.jpg
- 1826×837
- 2020/10/29 14:54
- 283.9 KB

- op_-_schulterarthrodese_fossum_2013_tobias_johnston_2012_fitzpatrick_et_al._2010_.jpg
- 2128×921
- 2020/10/29 14:54
- 311.4 KB

- op_-_schultergelenksinstabilitaet_piermattei_et_al_2017_.jpg
- 1256×702
- 2020/10/29 14:54
- 64.3 KB

- op_-_spinale_subarachnoidales_divertikulum_bismuth_2003_.jpg
- 932×603
- 2020/10/29 14:55
- 152.8 KB

- op_-_spinale_subarachnoidales_divertikulum_liu_et_al._2007_.jpg
- 922×1076
- 2020/10/29 14:54
- 245 KB

- op_-_splenektomie_fossum_2013_.jpg
- 1538×687
- 2020/10/29 14:54
- 383.7 KB

- op_-_stabilisierung_ces_weh_krauss_2007_.jpg
- 1750×445
- 2020/10/29 14:54
- 123.2 KB

- op_-_tarsalgelenksluxation_bandersatz_fossum_2013_.jpg
- 1600×510
- 2020/10/29 14:54
- 158.5 KB

- op_-_tarsalgelenksluxation_decamp_2017_.jpg
- 1511×570
- 2020/10/29 14:55
- 84.9 KB

- op_-_tarsalgelenksluxation_fossum_2013_decamp_2017_.jpg
- 1969×610
- 2020/10/29 14:54
- 157.4 KB

- op_-_tarsometatarsale_luxation_decamp_2017_.jpg
- 1748×529
- 2020/10/29 14:54
- 186.1 KB

- op_-_thorakotomie_tobias_johnston_2012_tk_hofheim_.jpg
- 1058×782
- 2020/10/29 14:54
- 177.3 KB

- op_-_thorakozenthese_tobias_2012_.jpg
- 1129×605
- 2020/10/29 14:54
- 179.5 KB

- op_-_thoraxdrainage_tobias_2012_.jpg
- 1479×743
- 2020/10/29 14:54
- 223.8 KB

- op_-_tibiafraktur_-_diaphysenfraktur_prinzipien_fossum_2013_.jpg
- 1404×647
- 2020/10/29 14:55
- 149.7 KB

- op_-_tibiafraktur_-_diaphysenfraktur_versorgung_fossum_2013_.jpg
- 1070×682
- 2020/10/29 14:54
- 87.3 KB

- op_-_tibiafraktur_-_distale_epiphysiolyse_piermattei_2017_.jpg
- 747×416
- 2020/10/29 14:54
- 55.9 KB

- op_-_tibiafraktur_-_proximale_metaphysenfraktur_piermattei_2017_.jpg
- 1062×624
- 2020/10/29 14:54
- 79.7 KB

- op_-_tibiafraktur_avulsion_tuberositas_tibiae_piermattei_2017_.jpg
- 1506×596
- 2020/10/29 14:54
- 155 KB

- op_-_tibiafraktur_malleolusfraktur_piermattei_2017_.jpg
- 1180×372
- 2020/10/29 14:55
- 75.4 KB

- op_-_trachealkollaps_zervikal_fossum_2013_m2_2017_.jpg
- 1600×737
- 2020/10/29 14:54
- 265.7 KB

- op_-_trachearesektion_tobias_2012_.jpg
- 1086×767
- 2020/10/29 14:54
- 182.1 KB

- op_-_tracheotomie_fossum_2013_.jpg
- 1062×796
- 2020/10/29 14:54
- 388.7 KB

- op_-_unterkiefer-symphysenfraktur_fossum_2013_.jpg
- 1352×447
- 2020/10/29 14:54
- 240.2 KB

- op_-_unterkieferfraktur_cerclage_2_tobias_johnston_2012_.jpg
- 1740×406
- 2020/10/29 14:54
- 79.2 KB

- op_-_unterkieferfraktur_cerclage_fossum_2013_.jpg
- 2284×435
- 2020/10/29 14:54
- 136.6 KB

- op_-_unterkieferfraktur_pinning_1_piermattei_et_al._2017_.jpg
- 1440×461
- 2020/10/29 14:55
- 108.5 KB

- op_-_unterkieferfraktur_platte_1_piermattei_et_al._2017_.jpg
- 1822×594
- 2020/10/29 14:54
- 173.4 KB

- op_-_unterkieferfraktur_zugang_fossum_2013_.jpg
- 1408×408
- 2020/10/29 14:54
- 103.6 KB

- op_-_ureteroneocystostomie_tobias_johnston_2012_.jpg
- 2093×529
- 2020/10/29 14:54
- 138.5 KB

- op_-_urethrostomie_hund_tobias_johnston_2012_.jpg
- 2443×1163
- 2020/10/29 14:54
- 420 KB

- op_-_urethrostomie_kater_tobias_johnston_2012_.jpg
- 2267×1263
- 2020/10/29 14:54
- 389.1 KB

- op_-_urethrostomie_lokalisation_und_naht_fossum_2013_.jpg
- 2577×597
- 2020/10/29 14:55
- 224.5 KB

- op_-_verband_othaematom_fossum_2013_.jpg
- 1455×397
- 2020/10/29 14:55
- 96.5 KB

- op_-_wundverschluss_1_tobias_johnston_2012_.jpg
- 1639×715
- 2020/10/29 14:55
- 183.6 KB

- op_-_wundverschluss_2_tobias_johnston_2012_.jpg
- 1591×886
- 2020/10/29 14:55
- 403 KB

- op_-_wundverschluss_schwenklappen_fossum_2013_.jpg
- 2686×1846
- 2020/10/29 14:54
- 748.5 KB

- op_-_zugaenge_zum_rektum_fossum_2013_.jpg
- 2822×772
- 2020/10/29 14:54
- 394.8 KB

- op_-_zugang_schulter_caudal_fossum_2013_.jpg
- 790×1158
- 2020/10/29 14:55
- 252.9 KB

- op_-_zugang_schulter_craniolateral_fossum_2013_.jpg
- 785×1470
- 2020/10/29 14:54
- 264.5 KB

- op_-_zugang_ventral-slot_fossum_2013_.jpg
- 1978×625
- 2020/10/29 14:55
- 214.3 KB

- op_-_zystotomie_fossum_2013_.jpg
- 1499×347
- 2020/10/29 14:54
- 107.3 KB

- op_gaumensegelkuerzung_findji_dupre_2007_.jpg
- 1647×1948
- 2020/10/29 14:55
- 928.7 KB

- op_gaumensegelkuerzung_fossum_2013_.jpg
- 826×709
- 2020/10/29 14:54
- 217.1 KB

- op_kieferschlinge_temporaer_lisa_affenzeller_2021_.jpg
- 1759×916
- 2021/06/06 17:37
- 219.1 KB

- op_lateralisation_endoskopie_post-op_tobias_johnston_2012_.jpg
- 1314×1002
- 2020/10/29 14:55
- 668.9 KB

- op_lateralisation_technik_fossum_2013_.jpg
- 931×1086
- 2020/10/29 14:54
- 364.8 KB

- op_lateralisation_zuegelung_tobias_johnston_2012_.jpg
- 1276×858
- 2020/10/29 14:54
- 229.4 KB

- op_lateralisation_zugang_tobias_johnston_2012_.jpg
- 755×1307
- 2020/10/29 14:54
- 385.8 KB

- op_nasenloecher_erweitern_tobias_johnston_2012_.jpg
- 1013×981
- 2020/10/29 14:54
- 375.9 KB

- op_resektion_evertierte_stimmtaschen_fossum_2013_.jpg
- 620×736
- 2020/10/29 14:54
- 189.9 KB

- op_tub.tibiaetransposition.jpg
- 4000×3000
- 2022/08/12 08:50
- 1.8 MB

- op-arthroskopieellbogenbealeetal.2003.jpg
- 2144×1238
- 2021/09/28 10:59
- 999.2 KB

- ophthalmologie_-_antatomie_auge_gefaesse_und_muskulatur_maggs_et_al._2008_.jpg
- 1032×758
- 2020/10/29 14:54
- 341.2 KB

- ophthalmologie_-_antatomie_auge_maggs_et_al._2008_.jpg
- 876×876
- 2020/10/29 14:54
- 390.9 KB

- ophthalmologie_-_autonome_invervation_auge_lorenz_et_al._2011_.jpg
- 871×809
- 2020/10/29 14:55
- 210.7 KB

- ophthalmologie_-_cherry_eye_m2_2018_.jpg
- 1560×1170
- 2020/10/29 14:54
- 974.1 KB

- ophthalmologie_-_distichiasis_foto_gelatt_et_al._2013_.jpg
- 632×474
- 2020/10/29 14:55
- 159.1 KB

- ophthalmologie_-_distichiasis_foto_stades_et_al._2007_.jpg
- 632×474
- 2020/10/29 14:54
- 159.1 KB

- ophthalmologie_-_distichiasis_op_gelatt_2011_.jpg
- 969×727
- 2020/10/29 14:54
- 270.4 KB

- ophthalmologie_-_distichiasis_schema_stades_et_al._2007_.jpg
- 422×562
- 2020/10/29 14:55
- 137 KB

- ophthalmologie_-_ektopische_zilien_foto_walde_et_al._2008_.jpg
- 502×376
- 2020/10/29 14:54
- 157.1 KB

- ophthalmologie_-_ektopische_zilien_op_walde_et_al._2008_.jpg
- 949×712
- 2020/10/29 14:54
- 275.8 KB

- ophthalmologie_-_ektopische_zilien_schema_stades_et_al._2007_.jpg
- 499×665
- 2020/10/29 14:54
- 93.9 KB

- ophthalmologie_-_evertierter_nickhautknorpel_maggs_et_al._2008_.jpg
- 640×449
- 2020/10/29 14:54
- 150.8 KB

- ophthalmologie_-_glaukom_linsenluxation_katarakt_uveitis_anterior_m2_2018_.jpg
- 1495×1079
- 2020/10/29 14:54
- 200.7 KB

- ophthalmologie_-_kolobom_iris_esson_2015_.jpg
- 770×577
- 2020/10/29 14:55
- 308.8 KB

- ophthalmologie_-_liddermoid_maggs_et_al._2008_.jpg
- 703×527
- 2020/10/29 14:54
- 242.1 KB

- ophthalmologie_-_lidtumor_squamoeses_karzinom_maggs_et_al._2008_.jpg
- 657×876
- 2020/10/29 14:54
- 106.2 KB

- ophthalmologie_-_op_cherry_eye_verankerung_maggs_et_al._2008_.jpg
- 547×848
- 2020/10/29 14:55
- 259.5 KB

- ophthalmologie_-_op_evertierter_nickhautknorpel_maggs_et_al._2008_.jpg
- 824×824
- 2020/10/29 14:55
- 236 KB

- ophthalmologie_-_op_resektion_nickhautdruese_maggs_et_al._2008_.jpg
- 535×839
- 2020/10/29 14:54
- 244.4 KB

- ophthalmologie_-_sehnervenbahnung_maggs_et_al._2008_.jpg
- 885×1172
- 2020/10/29 14:54
- 312.4 KB

- ophthalmologie_-_trichiais_foto_stades_et_al._2007_.jpg
- 665×499
- 2020/10/29 14:54
- 240 KB

- ophthalmologie_-_trichiais_schema_stades_et_al._2007_.jpg
- 575×601
- 2020/10/29 14:54
- 157.3 KB

- ophthalmologie_-_truebes_auge_quelle_unbekannt_.jpg
- 1153×915
- 2020/10/29 14:54
- 166.9 KB

- ophthalmologie_op_-_cherry_eye_morgan_pocket_technik_maggs_et_al._2008_.jpg
- 1839×717
- 2020/10/29 14:54
- 268 KB

- ophthalmologie_op_-_ektropium_kuhnt-szymanovsky-methode_stades_2007_.jpg
- 1125×844
- 2020/10/29 14:54
- 164.2 KB

- ophthalmologie_op_-_ektropium_y-blepharoplastik_maggs_et_al._2008_.jpg
- 650×866
- 2020/10/29 14:54
- 263.2 KB

- ophthalmologie_op_-_entropium_hotz-celsus_maggs_et_al._2008_.jpg
- 640×855
- 2020/10/29 14:55
- 227.4 KB

- ophthalmologie_op_-_entropium_nasale_kantoplastik_maggs_et_al._2008_.jpg
- 1322×821
- 2020/10/29 14:54
- 524.6 KB

- ophthalmologie_op_-_entropium_stades-methode_stades_2007_.jpg
- 1824×785
- 2020/10/29 14:55
- 298.6 KB

- ophthalmologie_op_-_enukleation_maggs_et_al._2008_.jpg
- 2462×1912
- 2020/10/29 14:55
- 676.2 KB

- ophthalmologie_op_-_konjunktival-flap_tobias_johnston_2012_.jpg
- 1297×693
- 2020/10/29 14:55
- 183.8 KB

- ophthalmologie_op_-_lidrandtumor_schiebelappenplastik_maggs_et_al._2008_.jpg
- 457×727
- 2020/10/29 14:54
- 192.3 KB

- ophthalmologie_op_-_lidrandtumor_wedgeresektion_maggs_et_al._2008_.jpg
- 1070×801
- 2020/10/29 14:55
- 201.3 KB

- ophthalmologie_op_-_nasenfaltenresektion_maggs_et_al._2008_.jpg
- 1114×1114
- 2020/10/29 14:54
- 402.8 KB

- ophthalmologie_op_-_nickhautschuerze_quelle_unbekannt_.jpg
- 602×269
- 2020/10/29 14:54
- 48.9 KB

- ophthalmologie_op_-_tarsoraphie_quelle_unbekannt_.jpg
- 650×434
- 2020/10/29 14:54
- 55.1 KB

- ophthalmologie_op_-_temporaer_entropium_maggs_et_al._2008_.jpg
- 640×855
- 2020/10/29 14:55
- 209.1 KB

- ophthalmologie_op_-chalizion_maggs_et_al._2008_.jpg
- 695×926
- 2020/10/29 14:54
- 195 KB

- ophthalmologie-abheilungulcusrecurrenspauli.png
- 859×561
- 2020/11/08 20:15
- 1.2 MB

- ophthalmologie-bulloesekeratopathiehdpauli.jpg
- 5184×3456
- 2020/11/08 20:15
- 7.3 MB

- ophthalmologie-cherryeye.jpg
- 5184×3456
- 2020/11/08 20:15
- 6.9 MB

- ophthalmologie-chronkeratitisinklpigmentierungbrachycephalerpauli.jpg
- 5184×3456
- 2020/11/08 20:15
- 5 MB

- ophthalmologie-distichienpauli.png
- 202×147
- 2020/11/08 20:16
- 91.3 KB

- ophthalmologie-einschmelzendesulkushdfloureszinpauli.jpg
- 5184×3456
- 2020/11/08 20:17
- 2.8 MB

- ophthalmologie-einschmelzendesulkushdpauli_1.jpg
- 5184×3456
- 2020/11/08 20:17
- 5.8 MB

- ophthalmologie-einschmelzendesulkushdpauli.jpg
- 5184×3456
- 2020/11/08 20:16
- 5.8 MB

- ophthalmologie-endothelialehhdystrophie.png
- 1114×742
- 2020/11/08 20:18
- 2.1 MB

- ophthalmologie-evertierternickhautknorpel.png
- 345×337
- 2020/11/08 20:18
- 339.6 KB

- ophthalmologie-glaukomhundpauli.jpg
- 1114×742
- 2020/11/08 21:04
- 174.1 KB

- ophthalmologie-glaukomktzpauli.jpg
- 5184×3456
- 2020/11/08 20:18
- 6 MB

- ophthalmologie-herpeskeratitisktzpauli.png
- 750×422
- 2020/11/08 20:18
- 869.2 KB

- ophthalmologie-hornhautdegenerationpauli.png
- 250×210
- 2020/11/08 20:19
- 157.8 KB

- ophthalmologie-hornhautdermoidpauli.png
- 1232×821
- 2020/11/08 21:00
- 2.3 MB

- ophthalmologie-hornhautnekrosektz.jpg
- 5184×3456
- 2020/11/08 20:19
- 5.8 MB

- ophthalmologie-hornhautnekrosektz1.jpg
- 5184×3456
- 2020/11/08 20:20
- 5.8 MB

- ophthalmologie-hundkcspigmentierung.jpg
- 250×165
- 2020/11/14 20:55
- 9.9 KB

- ophthalmologie-indolentesulkusktzfloureszinpauli.png
- 557×439
- 2020/11/08 20:20
- 674 KB

- ophthalmologie-iriszystepauli.jpg
- 5184×3456
- 2020/11/08 20:21
- 7.2 MB

- ophthalmologie-kcsmopspauli_1.jpg
- 5184×3456
- 2020/11/08 20:21
- 6.6 MB

- ophthalmologie-kcsmopspauli.jpg
- 5184×3456
- 2020/11/08 20:11
- 6.6 MB

- ophthalmologie-kollagenaseulkushdpauli_1.jpg
- 5184×3456
- 2020/11/23 22:37
- 6.4 MB

- ophthalmologie-kollagenaseulkushdpauli.jpg
- 5184×3456
- 2020/11/08 20:21
- 6.4 MB

- ophthalmologie-kollagenaseulkusktzpauli_1.jpg
- 5184×3456
- 2020/11/23 22:37
- 6.6 MB

- ophthalmologie-kollagenaseulkusktzpauli.jpg
- 5184×3456
- 2020/11/08 20:22
- 6.6 MB

- ophthalmologie-lipidkeratopthiepauli.png
- 250×175
- 2020/11/08 20:22
- 120.7 KB

- ophthalmologie-lymphomirisktz_1.jpg
- 1382×674
- 2020/11/08 21:32
- 153.3 KB

- ophthalmologie-lymphomirisktz.jpg
- 1382×674
- 2020/11/08 20:22
- 153.3 KB

- ophthalmologie-melanomktzpauli_1.jpg
- 5184×3456
- 2020/11/08 20:23
- 5.9 MB

- ophthalmologie-melanomktzpauli.jpg
- 5184×3456
- 2020/11/08 20:22
- 5.9 MB

- ophthalmologie-modifstadesmethodepauli.jpg
- 882×496
- 2020/11/08 20:23
- 59.3 KB

- ophthalmologie-modifstadespostop.png
- 803×652
- 2020/11/08 20:24
- 1.3 MB

- ophthalmologie-modifstadespostop1.png
- 406×270
- 2020/11/08 20:24
- 267.7 KB

- ophthalmologie-mopsaugepauli.jpg
- 5184×3456
- 2020/11/08 20:24
- 5.7 MB

- ophthalmologie-mopspauli.jpg
- 5184×3456
- 2020/11/08 20:24
- 6.6 MB

- ophthalmologie-mopspostopnasalekanthoplastikpauli.jpg
- 5184×3456
- 2020/11/15 21:05
- 5.9 MB

- ophthalmologie-mpp.jpg
- 220×225
- 2020/11/08 20:25
- 12.6 KB

- ophthalmologie-nasalekanthusplastikpauli_1.jpg
- 685×409
- 2020/11/15 21:09
- 44 KB

- ophthalmologie-nasalekanthusplastikpauli_2.jpg
- 685×409
- 2020/11/15 21:30
- 44 KB

- ophthalmologie-nasalekanthusplastikpauli_3.jpg
- 685×409
- 2020/11/15 21:32
- 44 KB

- ophthalmologie-nasalekanthusplastikpauli_4.jpg
- 685×409
- 2020/11/15 21:33
- 44 KB

- ophthalmologie-nasalekanthusplastikpauli.jpg
- 685×409
- 2020/11/08 20:25
- 44 KB

- ophthalmologie-pekarzinomkatzepauli.jpg
- 5184×3456
- 2020/11/08 20:25
- 5.6 MB

- ophthalmologie-postnasalekanthoplastikpauli.jpg
- 4019×2680
- 2020/11/08 20:25
- 2.4 MB

- ophthalmologie-prafundus1.jpg
- 200×170
- 2020/11/14 21:30
- 6.8 KB

- ophthalmologie-skleralertumorpauli.jpg
- 5184×3456
- 2020/11/08 21:34
- 5.1 MB

- ophthalmologie-stromalehornhautdystrophiepauli.jpg
- 155×110
- 2020/11/08 20:42
- 10 KB

- ophthalmologie-symblepharonpauli.jpg
- 5184×3456
- 2020/11/23 21:36
- 6.2 MB

- ophthalmologie-ulcusrecurrenspauli.png
- 577×526
- 2020/11/08 21:39
- 870.1 KB

- ophthalmologie-uveitishd.jpg
- 5184×3456
- 2020/11/15 20:36
- 5.8 MB

- ophthalmologie-uveitisktz1.jpg
- 5184×3456
- 2020/11/15 20:36
- 6.9 MB

- ophthalmologie-uveitisktzpauli.png
- 541×811
- 2020/11/15 20:35
- 1.1 MB

- opthalmologie-algerbrush.jpg
- 335×166
- 2020/11/14 20:23
- 5.9 KB

- opthalmologie-cctcorneoconjunctivaltransposition.jpg
- 1280×720
- 2020/11/14 22:18
- 93.3 KB

- opthalmologie-conjunctivitis_follicularis.jpg
- 337×256
- 2020/11/25 20:18
- 17.5 KB

- opthalmologie-hypertensiveretinopathie.jpg
- 250×120
- 2020/11/14 21:16
- 9.5 KB

- opthalmologie-netzhautabloesungdurchhypertensiveretinopathie.jpg
- 250×120
- 2020/11/14 21:16
- 8.2 KB

- opthalmologie-netzhautdysplasie.jpg
- 250×252
- 2020/11/14 21:44
- 7 KB

- opthalmologie-prafundus.jpg
- 227×228
- 2020/11/14 21:31
- 10.7 KB

- opthalmologie-symblepharonkatzepauli.png
- 1114×742
- 2020/11/23 22:01
- 2.2 MB

- orthop_c3_a4die-hdbewertungsschemalinnemann1998_1.jpg
- 718×820
- 2021/07/06 14:11
- 211.9 KB

- orthopaedie_-_bsv_hansen-typ-1_fossum_2013_.jpg
- 810×456
- 2020/10/29 14:54
- 52.8 KB

- orthopaedie_-_bsv_hansen-typ-2_fossum_2013_.jpg
- 778×456
- 2020/10/29 14:54
- 50.8 KB

- orthopaedie_-_ellbogengelenksluxation_johnson_2005_.jpg
- 1467×381
- 2020/10/29 14:54
- 38.4 KB

- orthopaedie_-_foraminostenose_rx_und_ct_m2_2018_.jpg
- 3775×1127
- 2020/10/29 14:55
- 533.1 KB

- orthopaedie_-_frakturbeurteilung_robinson_da_2014_.jpg
- 848×299
- 2020/10/29 14:55
- 59.3 KB

- orthopaedie_-_frakturtypen_roehrenknochen_fossum_2013_.jpg
- 832×624
- 2020/10/29 14:55
- 116.3 KB

- orthopaedie_-_fussverband_fossum_2013_.jpg
- 2013×441
- 2020/10/29 14:54
- 174.5 KB

- orthopaedie_-_hueftdysplasie_-_therapieoptionendiagramm.jpg
- 1733×1300
- 2020/10/29 14:55
- 401.6 KB

- orthopaedie_-_karpalbeugeverband_bojrab_2014_fossum_2013_.jpg
- 2033×478
- 2020/10/29 14:55
- 159.2 KB

- orthopaedie_-_knochenheilung_2_robinson_da_2014_.jpg
- 864×510
- 2020/10/29 14:55
- 93.2 KB

- orthopaedie_-_knochenheilung_dauer_robinson_da_2014_.jpg
- 417×252
- 2020/10/29 14:54
- 25.3 KB

- orthopaedie_-_knochenheilung_robinson_da_2014_.jpg
- 878×741
- 2020/10/29 14:55
- 135.4 KB

- orthopaedie_-_kopfverband_bojrab_2014_.jpg
- 1823×413
- 2020/10/29 14:54
- 112.4 KB

- orthopaedie_-_mediale_schulterinstabilitaet_abduktionstest_decamp_2016_.jpg
- 1159×448
- 2020/10/29 14:54
- 102.7 KB

- orthopaedie_-_ortolanitest_fossum_2013_.jpg
- 620×758
- 2020/10/29 14:55
- 245.2 KB

- orthopaedie_-_osteochondrom_diverse_quellen_.jpg
- 2336×616
- 2020/10/29 14:54
- 195.1 KB

- orthopaedie_-_plattengroessen_fixus_2018_.jpg
- 1219×804
- 2020/10/29 14:54
- 125.3 KB

- orthopaedie_-_resektion_verkalkung_m._supraspinatus_riegler_m_2018_vcot_1995_.jpg
- 1835×833
- 2020/10/29 14:54
- 261.8 KB

- orthopaedie_-_saeulenmodel_wirbelsaeule_wiesmann_nikoubashman_2014_.jpg
- 1310×725
- 2020/10/29 14:55
- 239 KB

- orthopaedie_-_salter-harris-frakturen_fossum_2013_.jpg
- 735×735
- 2020/10/29 14:55
- 106.3 KB

- orthopaedie_-_spica-splint_tobias_2012_.jpg
- 1035×492
- 2020/10/29 14:54
- 130 KB

- orthopaedie_-_teleskoping_m2_2018_.jpg
- 2051×1347
- 2020/10/29 14:54
- 1 MB

- orthopaedie_-_uebergangswirbel_typen_flueckiger_et_al._2009_.jpg
- 1003×719
- 2020/10/29 14:54
- 149.7 KB

- orthopaedie_-_uebergangswirbel_typen_julier-franz_2006_.jpg
- 1783×1925
- 2020/10/29 14:55
- 442.7 KB

- orthopaedie_-_verband_ehmer-schlinge_bojrab_2014_.jpg
- 2063×394
- 2020/10/29 14:55
- 88.1 KB

- orthopaedie_-_verband_schiene_ve_bojrab_2014_.jpg
- 2086×350
- 2020/10/29 14:54
- 144.8 KB

- orthopaedie_-_verband_velpeau-schlinge_bojrab_2014_.jpg
- 1883×391
- 2020/10/29 14:54
- 101.8 KB

- orthopaedie_-_verband_vorderfuss_gesamt_bojrab_2014_fossum_2013_.jpg
- 2439×603
- 2020/10/29 14:55
- 224.1 KB

- orthopaedie_-_vetamin_d_verlauf_esavs_2018_.jpg
- 3554×1050
- 2020/10/29 14:55
- 461.5 KB

- orthopaedie_-_wachstumsfugenschluss_tobias_johnston_2012_.jpg
- 846×692
- 2020/10/29 14:55
- 145.9 KB

- orthopaedie_-_wobbler_bandscheibenassoziert_tobias_2012_.jpg
- 1050×833
- 2020/10/29 14:54
- 395.3 KB

- orthopaedie_-_wobbler_klassifizierung_fossum_2013_.jpg
- 1047×451
- 2020/10/29 14:54
- 217 KB

- orthopaedie_-_wobbler_knochenassoziiert_tobias_2012_.jpg
- 1050×833
- 2020/10/29 14:54
- 377.8 KB

- orthopaedie-hdbewertungsschemalinnemann1998.jpg
- 718×820
- 2021/07/06 14:10
- 211.9 KB

- osteosynthese_-_abstuetzungsplattenosteosynthese_tobias_johnston_2012_.jpg
- 367×367
- 2020/10/29 14:54
- 42.3 KB

- osteosynthese_-_frakurscoring_biologie_fossum_2013_.jpg
- 984×586
- 2020/10/29 14:55
- 105.6 KB

- osteosynthese_-_frakurscoring_klinik_fossum_2013_.jpg
- 984×460
- 2020/10/29 14:54
- 83.2 KB

- osteosynthese_-_frakurscoring_mechanik_fossum_2013_.jpg
- 952×1054
- 2020/10/29 14:54
- 162.2 KB

- osteosynthese_-_kraefteuebertragung_platten_tobias_johnston_2012_.jpg
- 950×520
- 2020/10/29 14:54
- 219.5 KB

- osteosynthese_-_plate_rod_fossum_2013_.jpg
- 674×674
- 2020/10/29 14:55
- 114.1 KB

- osteosynthese_-_primaere_knochenheilung_tobias_johnston_2012_.jpg
- 1286×660
- 2020/10/29 14:54
- 313.9 KB

- osteosynthese_-_sekundaere_knochenheilung_tobias_johnston_2012_.jpg
- 1368×688
- 2020/10/29 14:54
- 437.7 KB

- osteosynthese_-_verplattungsarten_tobias_johnston_2012_.jpg
- 814×814
- 2020/10/29 14:54
- 165.2 KB

- osteosynthese_-_zugschraube_tobias_johnston_2012_.jpg
- 757×757
- 2020/10/29 14:54
- 94 KB

- papillomatose.jpg
- 5184×3456
- 2020/11/07 22:13
- 6.6 MB

- parasiten_-_auwaldzecke.jpg
- 300×486
- 2020/10/29 14:54
- 64.4 KB

- parasiten_-_braune_hundezecke.jpg
- 300×479
- 2020/10/29 14:55
- 47.8 KB

- parasiten_-_demodex_wikipedia_.jpg
- 768×1024
- 2020/10/29 14:54
- 435 KB

- parasiten_-_gemeiner_holzbock.jpg
- 300×480
- 2020/10/29 14:55
- 39.2 KB

- parasiten_-_herbstgrasmilbe_esccap_frankreich_.jpg
- 768×1024
- 2020/10/29 14:54
- 355.8 KB

- parasiten_-_hirschlausfliege_keine_lizenz_noetig_.jpg
- 768×1024
- 2020/10/29 14:55
- 539.8 KB

- parasiten_-_hundefloh_wikipedia_.jpg
- 768×1024
- 2020/10/29 14:55
- 719.9 KB

- parasiten_-_ototectes_cynotis_wikipedia_.jpg
- 1100×1467
- 2020/10/29 14:54
- 1 MB

- parasiten_-_sarcoptes_sacbies_wikipedia_.jpg
- 728×971
- 2020/10/29 14:54
- 592.8 KB

- parasiten_-_schmetterlingsmuecke_wikipedia_.jpg
- 255×300
- 2020/10/29 14:54
- 55.8 KB

- parasiten_ancyclostoma_caninum_pritt_2016_.jpg
- 361×481
- 2020/10/29 14:54
- 150.3 KB

- parasiten_capilaria_plica_quelle_unbekannt_.jpg
- 132×176
- 2020/10/29 14:54
- 19.2 KB

- parasiten_cryptosporidium_spp._quelle_unbekannt_.jpg
- 164×218
- 2020/10/29 14:55
- 30.4 KB

- parasiten_dipylidium_caninum_pritt_2016_2_.jpg
- 362×482
- 2020/10/29 14:54
- 143.3 KB

- parasiten_dipylidium_caninum_quelle_unbekannt_.jpg
- 158×211
- 2020/10/29 14:54
- 34.6 KB

- parasiten_echinococcus_spp._quelle_unbekannt_.jpg
- 155×206
- 2020/10/29 14:54
- 22.9 KB

- parasiten_giardien_oozysten_pritt_b_2018_.jpg
- 192×256
- 2020/10/29 14:54
- 22.9 KB

- parasiten_giardien_pritt_b_2018_.jpg
- 767×1022
- 2020/10/29 14:54
- 382.2 KB

- parasiten_isospora_spp._quelle_unbekannt_.jpg
- 153×204
- 2020/10/29 14:54
- 30.1 KB

- parasiten_taenia_spp._pritt_2016_.jpg
- 229×306
- 2020/10/29 14:55
- 36.6 KB

- parasiten_toxascaris_leonina_quelle_unbekannt_.jpg
- 168×223
- 2020/10/29 14:55
- 40.9 KB

- parasiten_toxocara_canis_pritt_2016_.jpg
- 405×540
- 2020/10/29 14:54
- 182.6 KB

- parasiten_toxocara_cati_pritt_2016_.jpg
- 169×225
- 2020/10/29 14:54
- 29.9 KB

- parasiten_toxoplasma_gondii_quelle_unbekannt_.jpg
- 149×199
- 2020/10/29 14:54
- 19.2 KB

- parasiten_trichuris_vulpis_ei_quelle_unbekannt_.jpg
- 158×211
- 2020/10/29 14:54
- 29.9 KB

- parasiten_trichuris_vulpis_quelle_unbekannt_.jpg
- 161×214
- 2020/10/29 14:54
- 25.1 KB

- patellaluxation_blockosteotomie_tobias_johnston_2012_.jpg
- 939×874
- 2020/10/29 14:55
- 308.4 KB

- patellaluxation_grade_di_dona_et_al._2018_.jpg
- 1918×1082
- 2020/10/29 14:54
- 218.1 KB

- patellaluxation_pathologie_decamp_et_al._2016_.jpg
- 386×852
- 2020/10/29 14:54
- 117.8 KB

- patellaluxation_wedgeosteotomie_tobias_johnston_2012_.jpg
- 853×1133
- 2020/10/29 14:54
- 352.2 KB

- pectusexcavatumexternersplint.jpg
- 1284×1257
- 2022/07/26 14:16
- 400.8 KB

- pectusexcavatuminternersplint.jpg
- 988×1182
- 2022/07/26 14:28
- 206.9 KB

- penisamputation_fossum_2013_.jpg
- 1870×902
- 2020/10/29 14:55
- 255.2 KB

- penisprolaps_fossum_2013_.jpg
- 1600×838
- 2020/10/29 14:55
- 189.4 KB
- pennhip_methode.pdf
- 2020/10/29 14:54
- 1.1 MB

- phimose_fossum_2013_.jpg
- 2476×752
- 2020/10/29 14:54
- 205.6 KB

- prognosebeimbsvforterre2021.jpg
- 3163×1100
- 2021/03/17 15:00
- 541.4 KB

- renin-angiotensin-aldosteron-system-raas.png
- 1024×571
- 2020/10/29 14:54
- 179.1 KB

- richtungsbezeichnungen.jpg
- 1527×444
- 2020/11/10 15:08
- 67.9 KB

- roentgenlagerung_abdomen.jpg
- 1137×615
- 2020/11/10 14:44
- 121.2 KB

- roentgenlagerung_ellbogen.jpg
- 2565×876
- 2020/11/10 14:44
- 303.1 KB

- roentgenlagerung_huefte.jpg
- 2218×867
- 2020/11/10 14:44
- 233.3 KB

- roentgenlagerung_humerus.jpg
- 2711×805
- 2020/11/10 14:44
- 219.4 KB

- roentgenlagerung_karpalgelenk_und_pfoten.jpg
- 2489×1800
- 2020/11/10 14:44
- 550.5 KB

- roentgenlagerung_knie.jpg
- 1625×920
- 2020/11/10 14:44
- 261.1 KB

- roentgenlagerung_kopf.jpg
- 1577×612
- 2020/11/10 14:44
- 159.8 KB

- roentgenlagerung_post_op_mit_implantaten.jpg
- 1583×778
- 2020/11/10 14:44
- 138.9 KB

- roentgenlagerung_schulter.jpg
- 3129×875
- 2020/11/10 14:44
- 402.6 KB

- roentgenlagerung_stressroentgen.jpg
- 1991×701
- 2020/11/10 14:44
- 200.4 KB

- roentgenlagerung_tarsus.jpg
- 2589×792
- 2020/11/10 14:44
- 187.8 KB

- roentgenlagerung_thorax.jpg
- 1393×692
- 2020/11/10 14:44
- 164.5 KB

- roentgenlagerung_tplo_prae-op.jpg
- 1690×665
- 2020/11/10 14:44
- 111.5 KB

- roentgenlagerung_unterarm.jpg
- 1052×1072
- 2020/11/10 14:44
- 105.6 KB

- roentgenlagerung_unterschenkel.jpg
- 2784×856
- 2020/11/10 14:44
- 184.2 KB

- roentgenlagerung_wirbelsaeule.jpg
- 1175×1206
- 2020/11/10 14:44
- 217.8 KB

- rt_-_trachealkollaps_grade_tobias_2012_.jpg
- 2109×995
- 2020/10/29 14:54
- 415.2 KB

- rueckenmarkshaeuteundliquor.jpg
- 1986×1125
- 2020/10/29 14:55
- 337.9 KB

- sehnennaehte.jpg
- 2105×1615
- 2020/10/29 14:54
- 285.5 KB
- sternaleluxationopchoi2004.pdf
- 2020/10/29 14:54
- 1.8 MB
- sternaleluxationopserra2015.pdf
- 2020/10/29 14:54
- 542.9 KB

- sticker_sarkom.png
- 545×848
- 2020/10/29 14:54
- 382.8 KB

- stressroentgenhyperextensionsverletzungkarpusbrinkeretal.2016.jpg
- 811×643
- 2020/10/29 14:54
- 105.3 KB
- systematik_bakterien.pdf
- 2020/10/29 14:54
- 119.5 KB

- teca-bo.jpg
- 2804×1006
- 2020/10/29 14:54
- 481.2 KB
- the_canine_meniscus_-_briggs_kk.pdf
- 2020/10/29 14:54
- 442.3 KB

- tplo_kraefteverteilung_tobias_johnston_2012_.jpg
- 623×872
- 2020/10/29 14:54
- 263.3 KB

- tplo_op-schema_fossum_2013_.jpg
- 1855×2177
- 2020/10/29 14:55
- 613.4 KB
- tplo_plate_system_weight_reference_chart.pdf
- 2020/10/29 14:54
- 747 KB
- tplo_rotationstabelle.pdf
- 2020/10/29 14:55
- 116.5 KB

- ugr_-_op_urethraprolaps_verankerungstechnik_martin_riegler_2018_.jpg
- 2644×2644
- 2020/10/29 14:54
- 1.2 MB

- ugt_-_harnsediment.jpg
- 1268×1125
- 2020/10/29 14:54
- 371 KB

- ugt_-_harnsteine.jpg
- 1335×1078
- 2020/10/29 14:54
- 125.5 KB

- ugt_-_katheterisierung_huendin_taylor_2016_.jpg
- 1279×1036
- 2020/10/29 14:55
- 237.1 KB

- ugt_-_katheterisierung_kaetzin_boyle_et_al._2010_.jpg
- 1025×769
- 2020/10/29 14:55
- 161.1 KB

- ugt_-_katheterisierung_kater_taylor_2016_.jpg
- 1020×444
- 2020/10/29 14:54
- 79.5 KB

- ugt_-_katheterisierung_ruede_taylor_2016_.jpg
- 2048×402
- 2020/10/29 14:54
- 185.4 KB

- ugt_-_restovarsyndrom_quelle_unbekannt_.jpg
- 1485×577
- 2020/10/29 14:54
- 188.8 KB

- ugt_-_rezidiv_urethraprolaps_nach_resektion_martin_riegler_2018_.jpg
- 3451×3451
- 2020/10/29 14:54
- 1.6 MB

- ugt_-_uroretrohydropropulsion_fossum_2013_.jpg
- 1296×837
- 2020/10/29 14:54
- 280.1 KB

- ugt-schwanzabrissprognosecouperetal.2020.jpg
- 4737×2306
- 2021/11/20 18:18
- 751.1 KB

- ultraschall_-_auge_1.jpg
- 1684×593
- 2020/10/29 14:54
- 137.6 KB

- ultraschall_-_lunge.jpg
- 1762×393
- 2020/10/29 14:55
- 105.7 KB

- urogenitaltrakt_-_pupd_abklaerung_kooistra_rijnberk_2010_.jpg
- 603×1220
- 2020/10/29 14:54
- 301.2 KB

- ventralebullaosteotomiejernejkmetec2014.jpg
- 2133×878
- 2021/03/19 14:03
- 434.5 KB

- vergiftung_-_tremorinduzierende_mykotoxine_gupta_et_al._2012_.jpg
- 516×675
- 2020/10/29 14:55
- 137.1 KB
- wiedner_forterreatlantoaxiale_instab.pdf
- 2021/11/12 17:44
- 582.1 KB

- zahnmedizin_-_nervenblock_n._infraorbitalis_gorrel_2004_.jpg
- 548×410
- 2020/10/29 14:55
- 64.9 KB

- zahnmedizin_-_nervenblock_n._mandibularis_extraorbital_gorrel_2004_.jpg
- 547×410
- 2020/10/29 14:55
- 58.2 KB

- zahnmedizin_-_nervenblock_n._mandibularis_infraorbital_gorrel_2004_.jpg
- 549×412
- 2020/10/29 14:55
- 63.8 KB

- zahnmedizin_-_nervenblock_n._mentalis_gorrel_2004_.jpg
- 547×411
- 2020/10/29 14:54
- 68.3 KB

- zahnmedizin_-_parodontitis_eickhoff_2014_.jpg
- 1079×666
- 2020/10/29 14:55
- 417.5 KB

- zugang_zum_sprunggelenk_decamp_et_al._2016_.jpg
- 1011×1534
- 2020/10/29 14:54
- 615.1 KB

- zytologie_-_analbeutelkarzinom_m2_2018_.jpg
- 896×671
- 2020/10/29 14:55
- 147.7 KB
- zytologie_-_anaplasmose_johannes_kriechbaumer_2018_.jpg
- 896×684
- 2020/10/29 14:54
- 261.7 KB

- zytologie_aszites_pyogranulomatoese_entzuendung_m2_2014_.jpg
- 896×684
- 2020/10/29 14:54
- 335.6 KB

- zytologie_entnahmetechnik_laboklin_2018_.jpg
- 2314×317
- 2020/10/29 14:55
- 359.7 KB

- zytologie_epitheliale_tumore_hirschberger_2016_.jpg
- 769×577
- 2020/10/29 14:54
- 104.9 KB

- zytologie_faerbetechnick_laboklin_2018_.jpg
- 2315×366
- 2020/10/29 14:55
- 301.1 KB

- zytologie_fremdkoerperriesenzelle_m2_2014_.jpg
- 896×684
- 2020/10/29 14:54
- 244.4 KB

- zytologie_fsa_katze_hirschberger_2016_.jpg
- 750×562
- 2020/10/29 14:54
- 248.8 KB

- zytologie_histiozytom_hund_hirschberger_2016_.jpg
- 749×561
- 2020/10/29 14:54
- 177 KB

- zytologie_lipom_m2_2014_.jpg
- 896×684
- 2020/10/29 14:54
- 281.5 KB

- zytologie_lymphatische_leukaemie_m2_2016_.jpg
- 896×684
- 2020/10/29 14:54
- 336.8 KB

- zytologie_lymphom_hund_m2_2016_.jpg
- 896×684
- 2020/10/29 14:54
- 243.4 KB

- zytologie_malignes_lymphom_hund_hirschberger_2016_.jpg
- 754×562
- 2020/10/29 14:54
- 317.1 KB

- zytologie_malignes_melanom_hund_hirschberger_2016_.jpg
- 753×564
- 2020/10/29 14:54
- 218.3 KB

- zytologie_malignitaetskriterien_1_m2_2014_.jpg
- 827×621
- 2020/10/29 14:54
- 178.1 KB

- zytologie_mastzelltumor_hund_hirschberger_2016_.jpg
- 750×560
- 2020/10/29 14:54
- 314.4 KB

- zytologie_mastzelltumor_praeputium_hund_m2_2014_.jpg
- 1792×1374
- 2020/10/29 14:54
- 593.7 KB

- zytologie_mesenchymale_tumore_hirschberger_2016_.jpg
- 765×574
- 2020/10/29 14:55
- 80.8 KB

- zytologie_plattenepithelkarzinom_hund_hirschberger_2016_.jpg
- 751×560
- 2020/10/29 14:54
- 183.5 KB

- zytologie_prostatakarzinom_hund_m2_2014_.jpg
- 896×684
- 2020/10/29 14:54
- 244.8 KB

- zytologie_rote_vogelmilbe_m2_2014_.jpg
- 896×684
- 2020/10/29 14:54
- 307 KB

- zytologie_rundzelltumore_hirschberger_2016_.jpg
- 1148×858
- 2020/10/29 14:54
- 164.1 KB

- zytologie_stickersarkoim_hund_hirschberger_2016_.jpg
- 748×561
- 2020/10/29 14:54
- 278.2 KB

- zytologie_thymomom_hund_m2_2015_.jpg
- 702×526
- 2020/10/29 14:54
- 189.6 KB

- zytologie_zelltyp_laboklin_2018_.png
- 590×368
- 2020/10/29 14:54
- 141 KB

- zytologie_zystitis_uratkristalle_kokken_m2_2014_.jpg
- 896×684
- 2020/10/29 14:54
- 135.9 KB
Datei
start.txt · Zuletzt geändert: 2021/11/20 17:52 von m2


